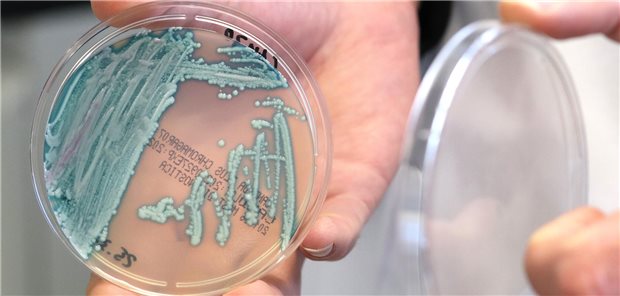
Candida auris: Der richtige Umgang mit einem expansiven Hefepilz Petrischale mit Pilzkolonien

Themenseite Mykosen
Themenseite - Mykosen
Krankenhäuser betroffen
ECDC meldet Anstieg von Infektionen mit Candidozyma auris
1
Invasive Candida-Infektionen
Modernes Echinocandin – optimierte Eigenschaften und klinische Vorteile
Meinung